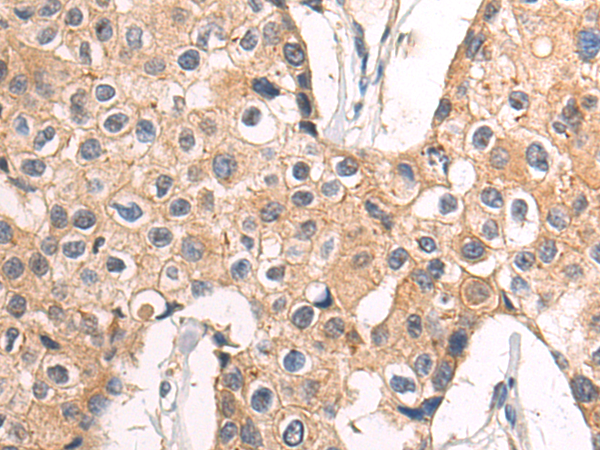

-
分类: 科研抗体货号: P09771别名: NET59应用: WB,IHC反应种属: Human, Mouse, Rat
-
分类: 科研抗体货号: P09753别名: GK001; MSTP041应用: WB,IHC反应种属: Human, Mouse, Rat
-
分类: 科研抗体货号: P09737别名: UBA4应用: WB反应种属: Human, Mouse
-
分类: 科研抗体货号: P09770别名: RSNL1; CLIPR59; CLIPR-59应用: WB反应种属: Human, Mouse
-
分类: 科研抗体货号: P09752别名: KIAA0652; PARATARG8应用: WB,IHC反应种属: Human, Mouse
-
分类: 科研抗体货号: P09736别名: RVB1; TIH1; ECP54; TIP49; ECP-54; INO80H; NMP238; PONTIN; TIP49A; NMP 238; Pontin52应用: WB,IHC反应种属: Human, Mouse, Rat
-
分类: 科研抗体货号: P09769别名: COD1; CDG2J应用: IHC反应种属: Human, Mouse
-
分类: 科研抗体货号: P09750别名: SHC; SHCA应用: WB,IHC反应种属: Human, Mouse, Rat
-
分类: 科研抗体货号: P09761别名: ZIP; ZC3H9; GPATC6; GPATCH6; ZC3HDC9; KIAA1847应用: WB,IHC反应种属: Human
-
分类: 科研抗体货号: P09768别名: PTB; PTB2; PTB3; PTB4; pPTB; HNRPI; PTB-1; PTB-T; HNRNPI; HNRNP-I应用: WB,IHC反应种属: Human, Mouse, Rat

鄂公网安备42018502007531号
鄂公网安备42018502007531号

